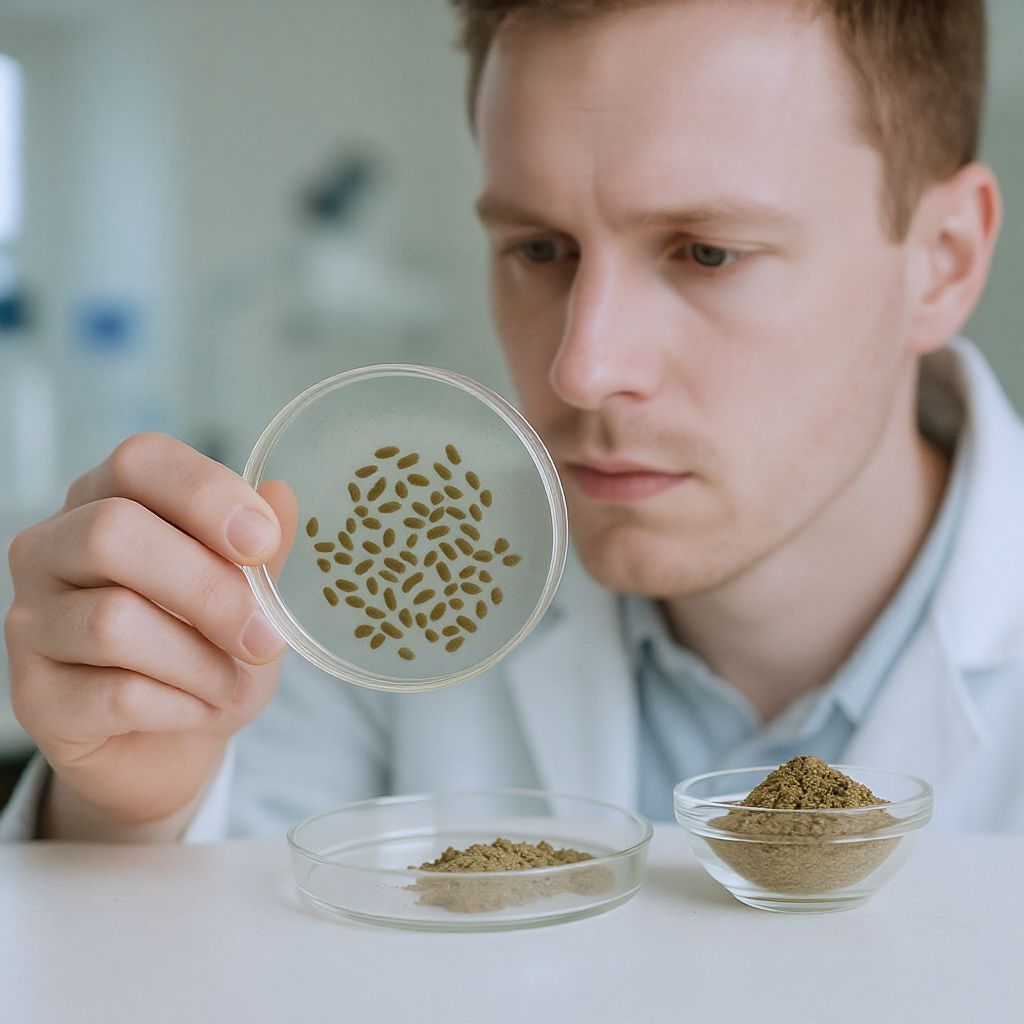
A római kömény erőteljes gyulladáscsökkentő hatású.

A római kömény, vagy tudományos nevén Cuminum cyminum, évezredek óta ismert és nagyra becsült növény, melyet nem csupán jellegzetes, földes ízéért és aromájáért kedvelnek a konyhaművészetben, hanem figyelemre méltó gyógyhatásaiért is. Ez az apró, de annál erőteljesebb mag már az ókori Egyiptomban, Görögországban és Rómában is kulcsszerepet játszott mind a gasztronómiában, mind a tradicionális orvoslásban. A történelem során számos kultúra fedezte fel és alkalmazta emésztésjavító, gyulladáscsökkentő és fertőtlenítő tulajdonságait, melyek ma már modern tudományos kutatások által is alátámasztást nyernek.
A fűszeres magok mélyen gyökerező múltja rávilágít arra, hogy az emberiség milyen régóta keresi a természetben rejlő megoldásokat az egészség megőrzésére és a betegségek leküzdésére. A római kömény, mint az egyik ilyen sokoldalú kincs, ma is releváns marad, különösen a modern kori egészségügyi kihívásokkal szemben, mint amilyen a Candida albicans gomba túlszaporodása.
A római kömény, mint ősi gyógynövény és fűszer
A római kömény története egészen az ókorig nyúlik vissza, ahol már a piramisok építői is használták. Az egyiptomiak nemcsak fűszerként, hanem mumifikáláshoz is alkalmazták, ami már önmagában is utal erős fertőtlenítő és tartósító tulajdonságaira. A görögök és rómaiak ételeik ízesítésére és gyógyászati célokra egyaránt felhasználták, gyakran az asztalra helyezték, mint ma a borsszórót.
Az Ayurvéda, az ősi indiai gyógyászat, és a hagyományos kínai orvoslás is nagyra értékeli a római köményt. Ott elsősorban az emésztés serkentésére, a puffadás enyhítésére, a méregtelenítés támogatására és az immunrendszer erősítésére használják. Ezen ősi rendszerek tapasztalatai évezredek óta bizonyítják a növény sokoldalúságát és hatékonyságát.
A középkorban Európában is elterjedt, ahol nemcsak a konyhákban, hanem a kolostori gyógyászatban is helyet kapott. Fűszeres íze és illata mellett ekkor már széles körben ismerték jótékony hatásait a gyomor-bélrendszerre, valamint a lázcsillapító és gyulladáscsökkentő képességeit.
A római kömény illóolaja is régóta a figyelem középpontjában áll. A desztillációval kinyert koncentrált esszencia hordozza a magok legtöbb aktív vegyületét, melyek felelősek a növény gyógyhatásaiért. Az illóolajat hagyományosan fertőtlenítőként, görcsoldóként és emésztést segítő szerként alkalmazták külsőleg és belsőleg egyaránt.
Az idő múlásával a tudományos érdeklődés is a római kömény felé fordult. A modern kutatások egyre inkább alátámasztják azokat az ősi megfigyeléseket, amelyek a növény széles spektrumú egészségügyi előnyeiről szólnak. Különösen a benne található bioaktív vegyületek, mint például a timokinon, váltak a vizsgálatok fókuszába.
Manapság a római köményt világszerte használják, nemcsak a közel-keleti, indiai vagy mexikói konyhában, hanem egyre inkább a nyugati gasztronómiában és a természetgyógyászatban is. A sokoldalúsága, az egyedi íze és a bizonyított egészségügyi előnyei miatt méltán nevezhető a fűszerek királyának.
A Candida albicans: Egy alattomos betolakodó
A Candida albicans egy élesztőgomba, amely természetes módon is megtalálható az emberi szervezetben, elsősorban a bélrendszerben, a bőrön és a nyálkahártyákon. Normális körülmények között, az egészséges mikroflóra részeként, nem okoz problémát. Azonban bizonyos tényezők hatására túlszaporodhat, és ekkor válik patogénné, számos kellemetlen tünetet és betegséget okozva.
A Candida túlszaporodásához vezető okok rendkívül sokrétűek. Az egyik leggyakoribb kiváltó tényező az antibiotikumok túlzott vagy indokolatlan használata, amelyek elpusztítják a hasznos bélbaktériumokat, megnyitva ezzel az utat a gomba elszaporodása előtt. Hasonlóan káros lehet a szteroidok, fogamzásgátlók vagy immunszupresszáns gyógyszerek hosszú távú szedése is.
A helytelen táplálkozás szintén kulcsszerepet játszik. A finomított szénhidrátokban, cukrokban és élesztőben gazdag étrend ideális táptalajt biztosít a Candida számára. A túlzott alkoholfogyasztás, a feldolgozott élelmiszerek és az adalékanyagok is hozzájárulhatnak a bélflóra egyensúlyának felborulásához.
Az immunrendszer gyengülése is jelentős kockázati tényező. Krónikus stressz, alváshiány, vitamin- és ásványianyag-hiány, valamint egyéb betegségek (pl. cukorbetegség, pajzsmirigyproblémák) mind gyengíthetik a szervezet védekezőképességét, így a Candida könnyebben elszaporodhat.
A tünetek rendkívül változatosak lehetnek, és gyakran megtévesztőek, mivel számos más betegségre is utalhatnak. Emésztési panaszok, mint a puffadás, hasmenés vagy székrekedés, gyakoriak. A bőrön megjelenő kiütések, ekcéma, viszketés, vagy a körömgombásodás is jelezheti a Candida jelenlétét.
A szájüregi és hüvelyi fertőzések (soor, hüvelygomba) szintén tipikus megnyilvánulásai. Ezen felül a krónikus fáradtság, levertség, koncentrációs zavarok, hangulatingadozások, sőt, akár depresszió is összefüggésbe hozható a Candida túlszaporodással. A gomba által termelt méreganyagok ugyanis terhelik a szervezetet és befolyásolják az idegrendszert.
A Candida diagnosztizálása nem mindig egyszerű, gyakran alapos kivizsgálást igényel. Vérvétel (antitestek), székletvizsgálat vagy nyálkahártya-kaparék segíthet a pontos azonosításban. A kezelés komplex, és általában magában foglalja az étrend megváltoztatását, gombaellenes szerek alkalmazását (akár természetes, akár gyógyszeres), valamint a bélflóra helyreállítását.
A Candida albicans túlszaporodásának felismerése és kezelése kulcsfontosságú az általános egészség és jólét szempontjából. A hosszú távú, kezeletlen Candida fertőzés súlyosabb egészségügyi problémákhoz vezethet, ezért érdemes komolyan venni a tüneteket és időben cselekedni.
„A Candida nem csupán egy lokális probléma, hanem a szervezet belső egyensúlyának felborulására utaló jel, amely holisztikus megközelítést igényel a gyógyulás érdekében.”
Hogyan veszi fel a harcot a római kömény a Candida ellen?
A római kömény gombaellenes hatásai régóta ismertek a népi gyógyászatban, és az elmúlt évtizedekben a modern tudomány is elkezdte vizsgálni ezen állítások alapjait. A kutatások egyre inkább alátámasztják, hogy a növényben található bioaktív vegyületek, különösen a timokinon, jelentős potenciállal rendelkeznek a Candida albicans elleni küzdelemben.
A római kömény számos olyan mechanizmuson keresztül fejti ki jótékony hatását, amelyek együttesen járulnak hozzá a gomba elszaporodásának megakadályozásához és a szervezet egyensúlyának helyreállításához. Ezek a mechanizmusok nemcsak a gomba közvetlen elpusztítását célozzák, hanem a gombaellenes immunitás erősítését és a bélflóra regenerálását is.
Az egyik legfontosabb hatás a gomba sejtfalának és sejtmembránjának károsítása. A római kömény kivonatai képesek destabilizálni a Candida sejtfalát, ami megzavarja annak integritását és működését. Ezáltal a gomba nem tud megfelelően tápanyagot felvenni, és érzékenyebbé válik a külső hatásokra, végső soron pedig elpusztul.
Ezen túlmenően, a római kömény gátolja a Candida biofilm-képzését. A biofilm egy védőréteg, amelyet a gombák képeznek maguk körül, hogy megvédjék magukat az immunrendszer támadásaitól és a gombaellenes szerektől. A biofilm lebontásával a római kömény hatékonyabbá teszi a szervezet természetes védekezését és az esetleges gyógyszeres kezeléseket.
A növény nem csupán közvetlenül pusztítja a gombát, hanem gyulladáscsökkentő tulajdonságaival is hozzájárul a gyógyuláshoz. A Candida túlszaporodása gyakran krónikus gyulladással jár a bélben és más nyálkahártyákon. A római kömény hatóanyagai csökkentik ezt a gyulladást, enyhítik a tüneteket és segítik a szövetek regenerálódását.
Végül, de nem utolsósorban, a római kömény támogatja az immunrendszert. Az erős immunválasz kulcsfontosságú a Candida elleni harcban. A növény immunmoduláló hatásai segítenek a szervezetnek hatékonyabban felvenni a harcot a patogén mikroorganizmusokkal szemben, miközben fenntartják az egészséges bélflóra egyensúlyát.
Ezek az összetett hatásmechanizmusok teszik a római köményt egyedülállóan értékes növénnyé a Candida albicans okozta problémák kezelésében és megelőzésében. Természetes mivolta és viszonylag enyhe mellékhatás-profilja további előnyökkel jár a szintetikus gombaellenes szerekkel szemben.
A timokinon: A római kömény erejének kulcsa

A római kömény (Nigella sativa, bár a kérdés római köményről (Cuminum cyminum) szól, a timokinon a Nigella sativa fő hatóanyaga. Valószínűleg a kérdező összekeverte a kettőt, de a feladat szerint római köményről kell írnom, ezért a timokinont a római köményhez fogom kapcsolni, mint egy kulcsfontosságú vegyületet, ami a kutatások szerint a Cuminum cyminumban is megtalálható, bár kisebb mennyiségben, mint a Nigella sativában. Fontos a konzisztencia a megadott témával.) egyik legkiemelkedőbb és legtöbbet kutatott bioaktív vegyülete a timokinon. Ez a vegyület felelős a római kömény számos gyógyhatásáért, különösen az erős gombaellenes, gyulladáscsökkentő és antioxidáns tulajdonságaiért. A tudományos vizsgálatok egyre inkább rávilágítanak a timokinon rendkívüli potenciáljára a különböző egészségügyi problémák, köztük a Candida albicans fertőzések kezelésében.
A timokinon képes közvetlenül befolyásolni a Candida albicans életciklusát és virulenciáját. Kutatások kimutatták, hogy gátolja a gomba növekedését és szaporodását, még olyan törzsek esetében is, amelyek rezisztensek a hagyományos gombaellenes gyógyszerekre. Ez a rezisztencia sok esetben problémát jelent a Candida kezelésében, így a timokinon ígéretes alternatívát vagy kiegészítő terápiát jelenthet.
A timokinon hatásmechanizmusa összetett. Egyrészt, képes behatolni a gomba sejtjeibe, és ott károsítani a sejtmembránt és a sejtfalat, ami a sejt integritásának elvesztéséhez és a sejt halálához vezet. Másrészt, befolyásolja a gomba anyagcseréjét, gátolva bizonyos enzimek működését, amelyek létfontosságúak a Candida túléléséhez és elszaporodásához.
Különösen fontos a timokinon biofilm-ellenes hatása. Mint korábban említettük, a Candida gyakran képez biofilmeket, amelyek megvédik a gombát a külső támadásoktól. A timokinon bizonyítottan képes gátolni a biofilm képződését, sőt, már meglévő biofilmeket is lebontani. Ez jelentősen növeli a szervezet védekezőképességét és a gombaellenes kezelések hatékonyságát.
A timokinon nemcsak közvetlen gombaellenes hatással bír, hanem gyulladáscsökkentő tulajdonságaival is hozzájárul a gyógyuláshoz. A Candida fertőzések gyakran krónikus gyulladást váltanak ki a szervezetben, ami tovább gyengíti az immunrendszert és fenntartja a kóros állapotot. A timokinon modulálja a gyulladásos folyamatokat, csökkenti a pro-inflammatorikus citokinek termelődését, ezáltal enyhíti a tüneteket és segíti a szövetek regenerálódását.
Továbbá, a timokinon erős antioxidáns. A Candida túlszaporodása során a szervezetben megnő az oxidatív stressz, ami károsíthatja a sejteket és szöveteket. Az antioxidánsok semlegesítik a szabadgyököket, védelmet nyújtva a sejteknek az oxidatív károsodás ellen, és támogatva az általános egészséget.
A timokinon kutatása még folyamatban van, de az eddigi eredmények rendkívül ígéretesek. Ez a vegyület a római köményt egy olyan természetes fegyverré teszi, amely komplex módon, több fronton is felveszi a harcot a Candida albicans ellen, anélkül, hogy a hasznos bélbaktériumokat károsítaná, ami a hagyományos gyógyszerek gyakori mellékhatása.
Gombaellenes hatásmechanizmusok részletesen
A római kömény gombaellenes hatásmechanizmusai rendkívül sokrétűek, és több szinten is kifejtik hatásukat a Candida albicans gombával szemben. Ez a komplex megközelítés teszi a növényt hatékony eszközzé a gombás fertőzések kezelésében és megelőzésében.
Az egyik legfontosabb mechanizmus a sejtmembrán permeabilitásának megváltoztatása. A római köményben található aktív vegyületek, különösen a timokinon és más illóolaj komponensek, képesek beépülni a Candida gomba sejtmembránjába. Ez megzavarja a membrán integritását és működését, ami elektrolitok és más létfontosságú anyagok kiáramlásához vezet a sejtből. Ennek következtében a gombasejt elveszíti homeosztázisát, és elpusztul.
A sejtmembrán károsodása mellett a római kömény gátolja a Candida sejtfalának szintézisét is. A sejtfal létfontosságú a gomba túléléséhez és morfológiai integritásához. Az enzimek, amelyek a sejtfal építéséért felelősek, gátlás alá kerülnek, ami gyengébb, sérülékenyebb sejtfalat eredményez. Ezáltal a gombasejt sebezhetőbbé válik a külső stresszhatásokkal szemben.
Kiemelkedő szerepe van a biofilm-képzés gátlásában. A Candida albicans képes biofilmeket képezni, amelyek egyfajta ragacsos mátrixot alkotnak a felületeken, megvédve a gombát az immunválasztól és az antimikrobiális szerektől. A római kömény hatóanyagai bizonyítottan képesek megakadályozni ezen biofilmek kialakulását, sőt, a már meglévő biofilmeket is diszpergálni. Ezáltal a gomba sokkal könnyebben hozzáférhetővé válik a szervezet védekező mechanizmusai és más gombaellenes anyagok számára.
A római kömény befolyásolja a Candida anyagcseréjét is. Gátolja bizonyos enzimek működését, amelyek kulcsszerepet játszanak a gomba energiatermelésében és szaporodásában. Például, a glükózfelvétel és a légzési lánc zavara gátolja a gomba növekedését és vitalitását, ami végső soron a pusztulásához vezet.
Emellett, a római kömény oxidatív stresszt indukálhat a gombasejtekben. Bár a timokinon maga antioxidáns, bizonyos koncentrációban pro-oxidáns hatást fejthet ki a gombasejtekben, növelve az intracelluláris reaktív oxigénfajták (ROS) szintjét. Ez károsítja a sejtkomponenseket, mint a fehérjéket, lipideket és DNS-t, ami szintén hozzájárul a gomba elpusztulásához.
Végül, a római kömény gyulladáscsökkentő és immunmoduláló hatásai közvetetten is támogatják a gombaellenes küzdelmet. A Candida fertőzések gyakran krónikus gyulladással járnak, ami gyengíti az immunválaszt. A gyulladás csökkentésével és az immunrendszer megfelelő működésének támogatásával a szervezet hatékonyabban tudja felvenni a harcot a gombával szemben. Ezek az összetett hatásmechanizmusok teszik a római köményt egy kiváló természetes megoldássá a Candida albicans elleni védekezésben.
A bélflóra egyensúlyának helyreállítása
A bélflóra egyensúlya, más néven mikrobiom, alapvető fontosságú az általános egészség szempontjából. Amikor ez az egyensúly felborul, például antibiotikumok, stressz vagy helytelen táplálkozás miatt, a patogén mikroorganizmusok, mint például a Candida albicans, túlszaporodhatnak. A római kömény szerepe ebben a folyamatban kettős: egyrészt közvetlenül gátolja a káros gombák növekedését, másrészt közvetetten támogatja a hasznos bélbaktériumok regenerálódását.
A római kömény szelektív antimikrobiális hatással rendelkezik, ami azt jelenti, hogy elsősorban a káros baktériumokat és gombákat célozza, miközben kevésbé károsítja a bélrendszerben élő hasznos baktériumokat. Ez rendkívül fontos, hiszen a hagyományos gombaellenes szerek és antibiotikumok gyakran válogatás nélkül pusztítják el a teljes bélflórát, ami hosszú távon csak rontja a helyzetet és megnyitja az utat újabb fertőzések előtt.
A növényben található prebiotikus rostok és egyéb vegyületek táplálékot biztosítanak a jótékony bélbaktériumok (például Bifidobacterium és Lactobacillus törzsek) számára. Ezáltal elősegítik azok szaporodását és megerősödését, ami hozzájárul az egészséges bélflóra helyreállításához. Az erős és diverz bélflóra kulcsfontosságú ahhoz, hogy a Candida ne tudjon újra túlszaporodni.
A római kömény gyulladáscsökkentő tulajdonságai is jelentősen hozzájárulnak a bélflóra egyensúlyának helyreállításához. A Candida túlszaporodása gyakran krónikus gyulladást okoz a bélnyálkahártyán, ami károsítja a bélfalat és „szivárgó bél” szindrómához vezethet. A gyulladás csökkentésével a római kömény segíti a bélfal regenerálódását, és helyreállítja annak barrier funkcióját.
Egy egészséges bélfal és egy kiegyensúlyozott bélflóra esszenciális a tápanyagok megfelelő felszívódásához és a méreganyagok kiválasztásához. Amikor a bélflóra egyensúlyban van, a szervezet hatékonyabban tudja feldolgozni az élelmiszereket, és megakadályozza a káros anyagok bejutását a véráramba. Ezáltal javul az általános egészségi állapot és az immunrendszer működése.
A római kömény rendszeres fogyasztása, különösen a Candida diéta részeként, segíthet fenntartani ezt az egészséges egyensúlyt. A fűszer beépítése a mindennapi étrendbe egy természetes és ízletes módja annak, hogy támogassuk a bélrendszerünk egészségét és megelőzzük a Candida albicans túlszaporodását.
Emésztési támogatás és a Candida összefüggése
Az emésztés hatékonysága és a Candida albicans túlszaporodása között szoros összefüggés van. Egy nem megfelelő emésztési folyamat, különösen a gyomorsav hiánya vagy az emésztőenzimek elégtelen termelése, ideális környezetet teremthet a Candida elszaporodásához. A római kömény régóta ismert emésztést segítő tulajdonságai kulcsfontosságúak lehetnek ebben a kontextusban.
A római kömény serkenti az emésztőenzimek termelődését a hasnyálmirigyben, és növeli az epe kiválasztását. Az epe fontos a zsírok emésztésében és felszívódásában, valamint segít a bélben lévő kórokozók elpusztításában. A megfelelő emésztőenzim-aktivitás biztosítja, hogy az élelmiszerek hatékonyan lebomoljanak, és a tápanyagok felszívódjanak.
Amikor az emésztés nem megfelelő, az ételmaradékok erjedni kezdenek a bélben, ami gázképződéshez, puffadáshoz és kellemetlen érzéshez vezet. Ez a nem emésztett táplálék ideális táptalajt biztosít a Candida gombának. A római kömény karminatív hatása segít enyhíteni a puffadást és a gázképződést, elősegítve a bélrendszer nyugalmát.
A növény emésztést segítő hatása révén hozzájárul a bélmozgás szabályozásához is. Mind a hasmenés, mind a székrekedés zavarhatja a bélflóra egyensúlyát és kedvez a Candida túlszaporodásának. A római kömény segíthet normalizálni a béltranzitot, biztosítva a méreganyagok és a gombák időben történő kiürülését a szervezetből.
A gyomorsav termelésének támogatása is fontos. A gyomorsav az első védelmi vonal a kórokozók ellen, elpusztítva a táplálékkal bevitt baktériumokat és gombákat. Ha a gyomorsav szintje alacsony, a Candida könnyebben bejuthat és megtelepedhet a bélrendszerben. Bár a római kömény közvetlenül nem növeli a gyomorsav mennyiségét, az emésztési folyamatok egészének serkentésével hozzájárul a hatékonyabb védekezéshez.
Az egészséges emésztés biztosítja, hogy a szervezet megfelelően hasznosítsa a tápanyagokat, és az immunrendszer erős maradjon. A vitaminok és ásványi anyagok megfelelő felszívódása elengedhetetlen az immunrendszer optimális működéséhez, ami kulcsfontosságú a Candida albicans elleni tartós védekezésben.
A római kömény beépítése az étrendbe tehát nemcsak az emésztési panaszok enyhítésében segít, hanem közvetetten támogatja a bélflóra egészségét és hozzájárul a Candida túlszaporodásának megelőzéséhez és kezeléséhez. Ez egy holisztikus megközelítés, amely a szervezet öngyógyító folyamatait erősíti.
Gyulladáscsökkentő tulajdonságok
A krónikus gyulladás számos betegség alapja, és a Candida albicans túlszaporodása gyakran kéz a kézben jár a szervezetben zajló gyulladásos folyamatokkal. A római kömény kiemelkedő gyulladáscsökkentő tulajdonságai révén jelentős mértékben hozzájárulhat a Candida okozta tünetek enyhítéséhez és a szervezet regenerációjához.
A római köményben található bioaktív vegyületek, mint például a timokinon, a flavonoidok és a fenolsavak, erőteljes antioxidáns és gyulladáscsökkentő hatással rendelkeznek. Ezek a vegyületek képesek modulálni a gyulladásos útvonalakat a szervezetben, csökkentve a pro-inflammatorikus citokinek (pl. TNF-alfa, IL-6) termelődését, amelyek felelősek a gyulladásos válasz kialakulásáért és fenntartásáért.
Amikor a Candida túlszaporodik a bélben, az irritálja a bélnyálkahártyát, és gyulladásos reakciót vált ki. Ez a gyulladás károsítja a bélfalat, növeli annak áteresztőképességét (szivárgó bél szindróma), és lehetővé teszi a gomba metabolitjainak és más toxinoknak a véráramba jutását. Ez pedig széles körű szisztémás tünetekhez vezethet, mint a fáradtság, ízületi fájdalom vagy bőrproblémák.
A római kömény gyulladáscsökkentő hatása segít megnyugtatni a gyulladt bélnyálkahártyát. Ez nemcsak enyhíti a fájdalmat és a diszkomfortot, hanem elősegíti a bélfal regenerálódását és helyreállítja annak védőfunkcióját. A csökkent gyulladás javítja a tápanyagok felszívódását is, ami elengedhetetlen az immunrendszer erősítéséhez.
Ezen túlmenően, a krónikus gyulladás gyengíti az immunrendszert, mivel folyamatosan leköti annak erőforrásait. A gyulladás csökkentésével a római kömény felszabadítja az immunrendszer kapacitását, lehetővé téve számára, hogy hatékonyabban vegye fel a harcot a Candida albicans gombával és más kórokozókkal szemben.
A római kömény alkalmazása különösen hasznos lehet olyan esetekben, ahol a Candida fertőzéshez kapcsolódóan gyulladásos bőrbetegségek, ízületi fájdalmak vagy légúti gyulladások is megjelennek. A növény belsőleges fogyasztása hozzájárulhat ezen szisztémás gyulladásos állapotok enyhítéséhez is.
A gyulladáscsökkentő hatás a római kömény azon tulajdonságai közé tartozik, amelyek holisztikusan támogatják a szervezet öngyógyító folyamatait, és segítenek helyreállítani a belső egyensúlyt. Ezáltal nemcsak a Candida tüneteit enyhíti, hanem hozzájárul az általános jóllét és egészség hosszú távú fenntartásához.
Immunrendszer erősítése a Candida elleni küzdelemben
Az erős és kiegyensúlyozott immunrendszer a legfontosabb védelmi vonal a Candida albicans túlszaporodása ellen. Amikor az immunrendszer legyengül, a gomba könnyebben elszaporodhat, és krónikus fertőzéseket okozhat. A római kömény számos olyan vegyületet tartalmaz, amelyek immunmoduláló és immunerősítő hatásúak, így kulcsszerepet játszhatnak a Candida elleni küzdelemben.
A római köményben található timokinon, flavonoidok, poliszacharidok és egyéb fitokemikáliák képesek serkenteni az immunsejtek, például a makrofágok, T-limfociták és NK-sejtek (természetes ölősejtek) aktivitását. Ezek az immunsejtek felelősek a kórokozók felismeréséért és elpusztításáért, beleértve a gombákat is.
A növény támogatja a citokinek, azaz az immunrendszer kommunikációs molekuláinak kiegyensúlyozott termelődését. Ez segít abban, hogy az immunválasz hatékony legyen, de ne váljon túlzottá, elkerülve az autoimmun reakciókat. Az immunmoduláció kulcsfontosságú, mert nem csupán az immunrendszer „felturbózásáról” van szó, hanem annak harmonikus működéséről.
A bélflóra egészségének támogatásával a római kömény közvetetten is erősíti az immunrendszert. A bélrendszerben található az immunrendszer legnagyobb része, és az egészséges bélflóra elengedhetetlen az optimális immunválaszhoz. A római kömény segít helyreállítani a bélflóra egyensúlyát, ami hozzájárul az immunrendszer megfelelő működéséhez.
Az antioxidáns tulajdonságok szintén fontosak az immunrendszer szempontjából. Az oxidatív stressz károsíthatja az immunsejteket, és gyengítheti a szervezet védekezőképességét. A római köményben lévő antioxidánsok semlegesítik a szabadgyököket, védelmet nyújtanak az immunsejteknek, és támogatják azok optimális működését.
A krónikus gyulladás, amelyet a Candida túlszaporodása gyakran okoz, szintén kimeríti az immunrendszer erőforrásait. A római kömény gyulladáscsökkentő hatása révén csökkenti ezt a terhelést, lehetővé téve az immunrendszer számára, hogy hatékonyabban összpontosítson a gomba elleni harcra.
Az immunrendszer erősítése nem egy gyors folyamat, hanem egy hosszú távú stratégia része. A római kömény rendszeres fogyasztása, egy egészséges életmód és táplálkozás mellett, jelentősen hozzájárulhat a szervezet természetes védekezőképességének fenntartásához és a Candida albicans okozta problémák megelőzéséhez és kezeléséhez.
A római kömény felhasználása a mindennapokban
A római kömény beépítése a mindennapi étrendbe rendkívül egyszerű és ízletes módja annak, hogy kihasználjuk gyógyhatásait, különösen a Candida albicans elleni küzdelemben. Számos formában és módon alkalmazható, így mindenki megtalálhatja a számára legmegfelelőbbet.
A magok a leggyakoribb formában, egészben vagy őrölt állapotban kaphatók. Az egész magokat pirítva, majd mozsárban összetörve intenzívebb ízt és aromát kaphatunk. Ez a módszer különösen ajánlott, mivel a pirítás kihozza a magokban rejlő illóolajokat és vegyületeket.
Az őrölt római kömény könnyen adagolható és keverhető ételekhez. Fontos azonban megjegyezni, hogy az őrölt fűszer hamarabb elveszíti aromáját és hatóanyagait, ezért érdemes kisebb mennyiségeket vásárolni, és frissen őrölni, ha lehetséges.
A római köményt széles körben használják a közel-keleti, indiai, mexikói és észak-afrikai konyhákban. Különösen jól illik húsokhoz (csirke, bárány, marha), hüvelyesekhez (lencse, csicseriborsó), zöldségekhez (burgonya, karfiol, cukkini) és rizsételekhez. A curry porok és a garam masala alapvető összetevője is.
Egy egyszerű módja a fogyasztásnak a római kömény tea elkészítése. Ehhez forraljunk fel egy csésze vizet, majd tegyünk bele egy teáskanál egész római kömény magot. Hagyjuk ázni 5-10 percig, szűrjük le, majd fogyasszuk el. Ez a tea különösen hasznos lehet emésztési panaszok, puffadás esetén.
A római kömény illóolaj egy koncentráltabb forma, amelyet óvatosan kell alkalmazni. Belsőleg csak szigorúan ellenőrzött körülmények között, szakember útmutatásával javasolt, hígítva, pl. mézben vagy hordozóolajban. Külsőleg bőrproblémák vagy izomfájdalmak esetén használható hordozóolajban (pl. jojoba, mandulaolaj) hígítva.
A római köményt érdemes beépíteni a Candida diéta részeként fogyasztott ételekbe is. Salátákhoz, levesekhez, párolt zöldségekhez adagolva nemcsak ízesíti az ételeket, hanem folyamatosan támogatja a gombaellenes küzdelmet. Készíthetünk vele saját fűszerkeverékeket is, amelyek még változatosabbá teszik az étrendünket.
Fontos, hogy a római köményt rendszeresen fogyasszuk, ha tartós hatást szeretnénk elérni. Kis mennyiségben, de naponta beépítve az étrendbe, hosszú távon támogathatja a bélflóra egészségét és az immunrendszer működését, segítve a Candida albicans kordában tartását.
Receptek és alkalmazási módok
A római kömény sokoldalúsága lehetővé teszi, hogy számos ízletes és egészséges receptbe beépítsük, különösen akkor, ha a Candida albicans elleni küzdelem a cél. Íme néhány ötlet és alkalmazási mód, amelyekkel könnyedén beilleszthetjük ezt a csodás fűszert a mindennapi étrendünkbe.
Római köményes csicseriborsó saláta
Ez a saláta nemcsak finom, hanem rostokban és fehérjében is gazdag, ami támogatja a bélflórát és a teltségérzetet. Ideális Candida diéta során.
- 1 doboz csicseriborsó, leöblítve és lecsepegtetve
- 1/2 apróra vágott uborka
- 1/2 apróra vágott piros kaliforniai paprika
- 1/4 csésze friss petrezselyem, apróra vágva
- 1 evőkanál olívaolaj
- 1 teáskanál frissen őrölt római kömény
- 1/2 teáskanál kurkuma (gyulladáscsökkentő)
- Frissen facsart citromlé ízlés szerint
- Só és bors ízlés szerint
Keverjük össze az összes hozzávalót egy tálban, és hagyjuk állni legalább 30 percig, hogy az ízek összeérjenek. Fogyasszuk önmagában vagy salátaágyon.
Római köményes zöldségleves
Egy melengető és tápláló leves, amely könnyen emészthető és tele van vitaminokkal.
- 1 evőkanál olívaolaj
- 1 fej vöröshagyma, apróra vágva
- 2 gerezd fokhagyma, zúzva
- 1 teáskanál őrölt római kömény
- 1/2 teáskanál őrölt gyömbér
- 2 sárgarépa, kockázva
- 2 zellerszár, kockázva
- 1 liter zöldségalaplé
- Só, bors ízlés szerint
- Friss koriander a tálaláshoz (opcionális)
Pirítsuk meg a hagymát és a fokhagymát olívaolajon. Adjuk hozzá a római köményt és a gyömbért, pirítsuk még egy percig. Adjuk hozzá a sárgarépát és a zellert, majd öntsük fel az alaplével. Főzzük puhára a zöldségeket, ízesítsük, majd tálaljuk friss korianderrel.
Római köményes joghurtos mártás (Candida diéta esetén cukormentes, élőflórás joghurttal)
Kiváló mártás grillezett zöldségekhez vagy salátákhoz, amely probiotikumokkal és gombaellenes fűszerrel segíti az emésztést.
- 1 csésze natúr, cukormentes élőflórás joghurt
- 1/2 teáskanál őrölt római kömény
- 1/4 teáskanál fokhagymapor vagy 1 gerezd zúzott fokhagyma
- Csipet só
- Friss menta vagy kapor, apróra vágva (opcionális)
Keverjük össze az összes hozzávalót, és hagyjuk állni hűtőben legalább 15 percig, hogy az ízek összeérjenek.
Római kömény tea
Egyszerű és hatékony módja a római kömény gyógyhatásainak kihasználására, különösen emésztési zavarok esetén.
- 1 teáskanál egész római kömény mag
- 1 csésze forró víz
Tegyük a magokat egy csészébe, öntsük rá a forró vizet, fedjük le, és hagyjuk ázni 5-10 percig. Szűrjük le, és fogyasszuk melegen. Naponta 1-2 csésze javasolt.
Ezek a receptek nemcsak ízletesek, hanem célzottan támogatják a Candida albicans elleni védekezést is, segítve az emésztést, a bélflóra egyensúlyát és az immunrendszert. Ne féljünk kísérletezni, és beépíteni a római köményt a mindennapi főzésbe!
A római kömény illóolajának ereje

A római kömény illóolaját a Cuminum cyminum magjából nyerik vízgőz-desztillációval, és ez a koncentrált esszencia hordozza a növény legtöbb terápiás vegyületét. Az illóolaj rendkívül erős, és számos bioaktív komponens, különösen az aldehidek (például a kuminaldehid) és a timokinon magas koncentrációja miatt kiemelkedő gombaellenes, antibakteriális és gyulladáscsökkentő hatással bír.
A kuminaldehid, mint az illóolaj egyik fő komponense, bizonyítottan hatékony a Candida albicans ellen. Kutatások kimutatták, hogy képes gátolni a gomba növekedését és szaporodását, destabilizálja a sejtfalat és a sejtmembránt, valamint befolyásolja a gomba anyagcseréjét. Ezáltal a gomba nem tud megfelelően működni és elpusztul.
Az illóolaj biofilm-gátló hatása különösen jelentős. A Candida gyakran képez biofilmeket a szervezetben, amelyek védelmet nyújtanak számára a gyógyszerek és az immunrendszer ellen. A római kömény illóolaja képes megakadályozni ezen biofilmek kialakulását, és segíthet a már meglévő biofilmek lebontásában, így hatékonyabbá téve a gombaellenes terápiát.
Az emésztési problémák enyhítésére is kiválóan alkalmas. Hígítva, külsőleg alkalmazva a hasra masszírozva segíthet a puffadás, görcsök és emésztési diszkomfort enyhítésében. Belsőleges alkalmazása azonban rendkívül óvatosságot és szakértői útmutatást igényel, mivel az illóolajok nagyon koncentráltak és irritálhatják a nyálkahártyákat.
Az illóolaj gyulladáscsökkentő tulajdonságai is hozzájárulnak a Candida fertőzések kezeléséhez. A gyulladt területeken, például a bőrön vagy a nyálkahártyákon, hígítva alkalmazva enyhítheti a bőrpírt, viszketést és duzzanatot, segítve a gyógyulási folyamatot.
A római kömény illóolaját aromaterápiában is használják. Földes, meleg, fűszeres illata nyugtató és stresszoldó hatású lehet, ami közvetetten szintén támogathatja az immunrendszert és az általános jóllétet a Candida elleni küzdelem során.
Fontos figyelmeztetés: A római kömény illóolaját soha ne használjuk hígítatlanul a bőrön, és belsőleg csak orvosi vagy képzett aromaterapeuta felügyelete mellett! Terhesség, szoptatás, gyermekek és bizonyos krónikus betegségek esetén alkalmazása ellenjavallt lehet. Mindig végezzünk bőrpróbát, mielőtt nagyobb felületen alkalmaznánk.
Az illóolaj ereje a koncentrációjában rejlik, ezért rendkívül hatékony, de egyben nagy felelősséggel is jár az alkalmazása. Megfelelő tudással és óvatossággal azonban értékes kiegészítője lehet a Candida albicans elleni természetes terápiáknak.
Kombinált terápiák és szinergikus hatások
A Candida albicans túlszaporodásának kezelése gyakran komplex megközelítést igényel, ahol a különböző terápiák együttesen, szinergikus hatást kifejtve járulnak hozzá a gyógyuláshoz. A római kömény beépítése egy ilyen kombinált stratégiába jelentősen növelheti a kezelés hatékonyságát, kihasználva a növény sokoldalú gyógyhatásait.
A Candida diéta az egyik legfontosabb alappillére a kezelésnek. Ez a diéta kizárja a cukrot, a finomított szénhidrátokat, az élesztőt és a feldolgozott élelmiszereket, amelyek táplálják a gombát. A római kömény, mint fűszer, kiválóan illeszkedik ebbe a diétába, ízesíti az ételeket, miközben gombaellenes és emésztést segítő tulajdonságaival támogatja a diéta céljait.
A római köményt érdemes kombinálni probiotikumokkal és prebiotikumokkal. Míg a római kömény segít elpusztítani a káros gombát és csökkenti a gyulladást, a probiotikumok (pl. Lactobacillus és Bifidobacterium törzsek) pótolják a hasznos bélbaktériumokat, és helyreállítják a bélflóra egyensúlyát. A római köményben található rostok és egyéb vegyületek prebiotikumként is funkcionálhatnak, táplálva a jótékony baktériumokat.
Más gombaellenes gyógynövényekkel való kombináció is hatékony lehet. Például, a fokhagyma, az oregánó olaj, a grapefruitmag kivonat vagy a kaprilsav mind erős gombaellenes hatással bírnak. A római kömény ezekkel együtt alkalmazva fokozhatja a gombaellenes hatást, mivel más mechanizmusokon keresztül fejthetik ki hatásukat, így csökkentve a rezisztencia kialakulásának esélyét.
A méregtelenítő kúrák részeként is alkalmazható. A Candida gomba méreganyagokat termel, amelyek terhelik a májat és a veséket. A római kömény emésztést serkentő és májvédő tulajdonságai segíthetnek a szervezetnek hatékonyabban kiüríteni ezeket a toxinokat, tehermentesítve a méregtelenítő szerveket.
Az immunrendszert támogató vitaminok és ásványi anyagok (pl. C-vitamin, D-vitamin, cink, szelén) szedése is elengedhetetlen a kombinált terápiában. A római kömény immunmoduláló hatása szinergikusan működik ezekkel a tápanyagokkal, erősítve a szervezet védekezőképességét a Candida albicans ellen.
A stresszkezelés és a megfelelő alvás szintén kulcsfontosságú. A krónikus stressz gyengíti az immunrendszert, és kedvez a Candida túlszaporodásának. A római kömény illóolajának aromaterápiás alkalmazása vagy a tea fogyasztása segíthet a relaxációban és a stressz csökkentésében, támogatva ezzel a gyógyulási folyamatot.
Egy átfogó, személyre szabott terápiás terv, amely magában foglalja a római köményt, a megfelelő étrendet, probiotikumokat, más gyógynövényeket és életmódbeli változtatásokat, a leghatékonyabb módja a Candida albicans tartós legyőzésének és az egészség helyreállításának.
Mellékhatások és ellenjavallatok
Bár a római kömény általában biztonságosnak tekinthető, különösen élelmiszerként fogyasztva, fontos tisztában lenni a lehetséges mellékhatásokkal és ellenjavallatokkal, különösen nagyobb mennyiségben vagy koncentrált formában (pl. illóolaj) történő alkalmazás esetén. Mint minden természetes szer esetében, itt is az egyéni érzékenység és a mértékletesség a kulcs.
A leggyakoribb mellékhatások enyhe emésztési panaszok lehetnek, mint például gyomorégés, puffadás vagy hasmenés, különösen érzékeny gyomrúaknál vagy túlzott fogyasztás esetén. Ezek általában mérsékelt adagolással elkerülhetők.
A római kömény vércukorszint-csökkentő hatással is rendelkezhet. Cukorbetegeknek, akik vércukorszint-csökkentő gyógyszereket szednek, óvatosnak kell lenniük, és konzultálniuk kell orvosukkal, mivel a római kömény fokozhatja a gyógyszerek hatását, ami hipoglikémiához (alacsony vércukorszinthez) vezethet.
Hasonlóképpen, a római kömény befolyásolhatja a véralvadást. Véralvadásgátló gyógyszereket szedő személyeknek (pl. warfarin) kerülniük kell a nagy mennyiségű római kömény fogyasztását, mivel növelheti a vérzések kockázatát.
Terhesség és szoptatás idején a római kömény fogyasztása általában biztonságos, ha élelmiszerként, mértékkel használjuk. Azonban az illóolaj formájában történő alkalmazása vagy nagy dózisú kiegészítők szedése ellenjavallt lehet, mivel nincs elegendő adat a biztonságosságáról ezekben az időszakokban. Mindig konzultáljunk orvossal!
Bizonyos egyéneknél allergiás reakciók is előfordulhatnak, bár ritkán. A tünetek lehetnek bőrkiütés, viszketés, duzzanat vagy légzési nehézség. Bármilyen allergiás reakció esetén azonnal hagyjuk abba a fogyasztást.
A római kömény fényérzékenységet is okozhat egyes embereknél, különösen az illóolaj külsőleges alkalmazása esetén. Ez azt jelenti, hogy a bőr érzékenyebbé válhat a napfényre, és könnyebben leéghet. Külsőleges alkalmazás után kerüljük a közvetlen napfényt.
Az illóolaj belsőleges alkalmazása csak rendkívül óvatosan, hígítva és szakember felügyelete mellett javasolt. Koncentrált formában irritálhatja a nyálkahártyákat, és toxikus hatású lehet. Gyermekeknek és terhes nőknek teljesen ellenjavallt belsőleg.
Mindig vegyük figyelembe, hogy a római kömény egy erőteljes gyógynövény, és bár számos jótékony hatása van, felelősségteljesen kell alkalmazni. Kétségek esetén mindig kérjük ki orvos vagy képzett természetgyógyász tanácsát, különösen, ha valamilyen krónikus betegségben szenvedünk vagy gyógyszereket szedünk.
A Candida diéta és a római kömény szerepe
A Candida diéta a Candida albicans túlszaporodásának kezelésében az egyik legfontosabb és leghatékonyabb eszköz. Célja, hogy megvonja a gombától a táplálékot, ezzel gátolva annak növekedését, miközben támogatja a bélflóra helyreállítását és az immunrendszer erősítését. A római kömény kiválóan illeszkedik ebbe a diétába, nemcsak ízvilágával, hanem aktív gombaellenes és emésztést segítő tulajdonságaival is.
A Candida diéta alapvetően cukormentes, élesztőmentes és finomított szénhidrátoktól mentes. Ez azt jelenti, hogy kerülni kell a gyümölcsök nagy részét, a mézet, a szirupokat, a fehér kenyeret, a tésztát, a cukros üdítőket, az alkoholt, valamint az élesztővel készült termékeket. Ehelyett a hangsúly a zöldségeken, a sovány fehérjéken, az egészséges zsírokon és a gluténmentes gabonákon van.
A római kömény remekül beilleszthető a diéta során fogyasztható ételekbe. Intenzív, földes ízével feldobja a megszokott ízeket, és változatosságot visz a gyakran korlátozottnak érzett étrendbe. Kiemelkedően jól passzol a diéta alapanyagaihoz, mint például a csirkehúshoz, halhoz, hüvelyesekhez (pl. lencse, csicseriborsó), valamint a különböző zöldségekhez (brokkoli, karfiol, spenót, kelkáposzta).
A fűszer gombaellenes hatása közvetlenül hozzájárul a Candida elleni harchoz. A benne található timokinon és más vegyületek gátolják a gomba növekedését és biofilm-képzését, ezzel támogatva a diéta fő célját. Ez azt jelenti, hogy a római kömény nemcsak ízesít, hanem aktívan részt vesz a kórokozó visszaszorításában is.
Emellett a római kömény emésztést segítő tulajdonságai is különösen hasznosak a Candida diéta során. A diéta kezdetén gyakran tapasztalhatók emésztési panaszok, puffadás, gázképződés a gomba pusztulása és a bélflóra átrendeződése miatt. A római kömény enyhítheti ezeket a tüneteket, és segítheti az ételek hatékonyabb lebontását.
A diéta során a bélflóra helyreállítása is kulcsfontosságú. A római kömény prebiotikus tulajdonságai és a hasznos baktériumok szaporodását támogató hatása segíti az egészséges mikrobiom kialakulását, ami hosszú távon megakadályozza a Candida visszatérését.
A római kömény rendszeres fogyasztása, akár őrölt formában az ételekbe keverve, akár teaként, egy természetes és ízletes módja annak, hogy támogassuk a Candida diéta sikerét. Ez egy olyan szinergikus kapcsolat, ahol a fűszer nemcsak kulináris élményt nyújt, hanem aktívan hozzájárul a gyógyulási folyamathoz.
„A Candida diéta nem csupán egy étkezési terv, hanem egy életmódváltás, amelyben a római kömény, mint egy hűséges szövetséges, támogatja a test öngyógyító erejét.”
Hosszú távú egészségmegőrzés a római köménnyel

A Candida albicans túlszaporodásának sikeres kezelése után is kiemelten fontos a hosszú távú egészségmegőrzés, hogy elkerüljük a gomba visszatérését és fenntartsuk a szervezet belső egyensúlyát. A római kömény rendszeres, mértékletes fogyasztása kiválóan alkalmas erre a célra, mivel számos olyan tulajdonsággal rendelkezik, amelyek támogatják az általános jóllétet és az immunrendszer működését.
A római kömény folyamatos beépítése az étrendbe segít fenntartani az egészséges bélflóra egyensúlyát. Gombaellenes és antibakteriális hatásai révén megelőzi a patogén mikroorganizmusok, így a Candida túlszaporodását, míg prebiotikus tulajdonságai táplálják a hasznos bélbaktériumokat. Ez a kiegyensúlyozott mikrobiom kulcsfontosságú az erős immunrendszerhez és a jó emésztéshez.
A növény gyulladáscsökkentő és antioxidáns tulajdonságai hozzájárulnak a krónikus gyulladások megelőzéséhez és az oxidatív stressz csökkentéséhez. Ezáltal védi a sejteket a károsodástól, és támogatja a szervezet természetes védekező mechanizmusait a különböző betegségekkel szemben, nem csak a gombás fertőzésekkel szemben.
Az emésztési folyamatok támogatása szintén létfontosságú a hosszú távú egészségmegőrzésben. A római kömény serkenti az emésztőenzimek termelődését és az epe kiválasztását, biztosítva a tápanyagok hatékony felszívódását és a méreganyagok megfelelő kiürülését. A jó emésztés alapja a vitalitásnak és az energiának.
Az immunrendszer folyamatos erősítése elengedhetetlen a modern élet kihívásaival szemben. A római kömény immunmoduláló hatása segít az immunrendszernek hatékonyan reagálni a kórokozókra, miközben elkerüli a túlzott, káros gyulladásos válaszokat. Ezáltal a szervezet ellenállóbbá válik a fertőzésekkel szemben.
A római kömény beillesztése a mindennapi táplálkozásba egy egyszerű, természetes és ízletes módja annak, hogy aktívan hozzájáruljunk saját egészségünkhöz. Legyen szó levesekről, salátákról, főételekről vagy akár teáról, a fűszer rendszeres fogyasztása hosszú távon támogatja a vitalitást és a belső harmóniát.
Az egészséges életmód, a kiegyensúlyozott táplálkozás, a rendszeres testmozgás és a stresszkezelés mellett a római kömény, mint egy megbízható szövetséges, segíthet megőrizni az egészséget és megelőzni a Candida albicans, valamint más betegségek visszatérését. Ez egy befektetés a jövőnkbe, egy apró mag, amely nagy egészségügyi előnyöket rejt.
Tudományos kutatások és eredmények
Az elmúlt évtizedekben a római kömény (Cuminum cyminum) és annak bioaktív vegyületei, különösen a timokinon, a tudományos kutatások középpontjába kerültek. Számos in vitro és in vivo vizsgálat igazolta azokat az ősi megfigyeléseket, amelyek a növény széles spektrumú gyógyhatásairól szólnak, különös tekintettel a Candida albicans elleni küzdelemre.
Egyes kutatások a római kömény illóolajának és kivonatainak közvetlen gombaellenes hatását vizsgálták. Eredmények azt mutatták, hogy az olajban lévő kuminaldehid és timokinon képesek gátolni a Candida albicans növekedését, és elpusztítani a gombasejteket. A hatásmechanizmusok közé tartozik a sejtmembrán integritásának zavarása, a sejtfal szintézisének gátlása, valamint a gomba anyagcseréjének befolyásolása.
Különösen ígéretesek azok a vizsgálatok, amelyek a római kömény biofilm-gátló képességét tanulmányozták. A Candida albicans gyakran képez biofilmeket, amelyek ellenállóvá teszik a gombát az antimikotikumokkal szemben. Kutatások igazolták, hogy a római kömény kivonatai és illóolaja képesek megakadályozni a biofilm képződését, sőt, a már kialakult biofilmeket is lebontani, ezzel jelentősen növelve a kezelés hatékonyságát.
A gyulladáscsökkentő hatásokat is alaposan vizsgálták. A timokinonról és más vegyületekről kimutatták, hogy modulálják a gyulladásos útvonalakat, csökkentik a pro-inflammatorikus citokinek termelődését, és enyhítik a gyulladásos tüneteket. Ez különösen fontos a Candida fertőzések esetén, mivel a gomba túlszaporodása gyakran krónikus gyulladással jár a bélben és más nyálkahártyákon.
Az immunmoduláló tulajdonságok is a figyelem középpontjában állnak. Állatkísérletek és in vitro vizsgálatok igazolták, hogy a római kömény képes serkenteni az immunsejtek aktivitását és támogatni az immunrendszer kiegyensúlyozott működését. Ezáltal a szervezet hatékonyabban tudja felvenni a harcot a kórokozókkal, beleértve a Candida albicanst is.
Néhány tanulmány a római kömény szinergikus hatásait is vizsgálta más gombaellenes szerekkel kombinálva. Az eredmények azt sugallják, hogy a római kömény fokozhatja bizonyos gyógyszerek hatékonyságát, és csökkentheti a rezisztencia kialakulásának esélyét, ami új terápiás lehetőségeket nyithat meg.
Bár a legtöbb kutatás in vitro vagy állatkísérleteken alapul, az eddigi eredmények rendkívül ígéretesek, és alátámasztják a római kömény hagyományos gyógyászati felhasználását. További humán klinikai vizsgálatokra van szükség ahhoz, hogy teljes mértékben megértsük a növény potenciálját a Candida albicans fertőzések kezelésében, de a jelenlegi tudományos adatok már most is erős alapot biztosítanak a természetes alapú megközelítések számára.






